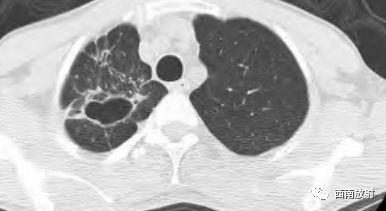
非结核分枝杆菌( NTM)-8

非结核分枝杆菌( NTM)
发布时间:2022-12-03
发布时间:2022-12-03
非结核分枝杆菌( NTM)
非结核分枝杆菌(NTM)
非结核分枝杆菌感染(NTMB)
鸟复合分枝杆菌(MAC
同义词
除结核外的分枝杆菌(MOTT
温夫人综合征
结节性支气管扩张型NTMB的最初描述
非结核分枝杆菌( NTM)是除结核分枝杆菌复合群和麻风分枝杆菌以外的一大类分枝杆菌的总称。NTM引起的肺部病变称为非结核分枝杆菌肺病 ( nontuberculous mycobacteria- pulmonary disease,NTM-PD)是分枝杆菌感染中的一个重要组成部分,NTM-PD的临床症状和影像学表现与肺结核极为相似,容易误诊而延误治疗。引起 NTM-PD 的常见菌种有胞内分枝杆菌、鸟分枝杆菌、脓肿分枝杆菌和堪萨斯分枝杆菌[1]
最佳诊断线素
2、纤维空洞型:上叶空洞性病变及胸膜增厚
3、热浴肺:弥漫的小叶中央磨玻璃微结节。
CT征象
主要的征象包括:
小叶中心结节( 树芽征) 、肺小叶实变、肺段及肺大叶实变、空洞、支气管扩张、病灶内钙化灶、肺不张、肺气肿、肺大疱、肺损毁、纵隔肺门淋巴结肿大( 气管隆突下淋巴结直径≥1.5cm,其他纵隔内淋巴结直径≥1.0cm) 、淋巴结钙化、胸腔积液、胸膜增厚。
王安龙,司马斌,保春华.等[4]研究137例NTM-PD显示:
1、胞内分枝杆菌组、鸟分枝杆菌组、脓肿分枝杆菌与堪萨斯分枝杆菌组组间 CT 征象有重叠,肺小叶实变、肺段及肺大叶实变、肺不张、肺气肿、肺大疱、肺损毁、纵隔肺门淋巴结肿大、淋巴结钙化、胸腔积液等 CT 征象在 4 组之间差别无统计学意义。
2、肺小叶实变是4个菌种组中常见的CT征象,其病理多表现为淋巴细胞、巨噬细胞浸润和干酪样坏死为主的渗出性反应,干酪样坏死的程度和范围相对较低。3、非结核分枝杆菌毒力较弱,干酪性肺炎的段及肺大叶实变少见。
4、肺不张、肺气肿、肺大疱、肺损毁、纵隔肺门淋巴结肿大、淋巴结钙化、胸腔积液等CT征象在4个菌种组均少见。

▲胞内分枝杆菌肺病,左肺上叶空洞。

▲胞内分枝杆菌肺病,小叶中心结节(树芽征)

▲胞内分枝杆菌肺病,小叶中心结节(树芽征),双肺多发厚壁空洞。

▲胞内分枝杆菌肺病,右肺中叶支气管扩张,右肺下叶小叶中心结节

▲女,66 岁,鸟分枝 杆菌肺病,右肺上叶支气管扩张伴多发小叶中心结节(树芽征)

▲男,79 岁,脓肿分枝杆菌肺病,两肺多发支气管扩张伴小叶中心结节( 树芽征)
▲男,50 岁,堪萨斯分枝杆菌肺病,右肺上叶薄壁空洞。

▲非结核分支杆菌肺病(龟-脓肿复合群分支杆菌)。
小叶中心结节( 树芽征) 在胞内分枝杆菌组中最常见,其次为鸟分枝杆菌组及脓肿分枝杆菌组,在堪萨斯分枝杆菌组中出现最少。小叶中心结节(树芽征)的形成是由细支气管腔内存在坏死组织及(或)小叶内散在肉芽肿所致,同时反映了支气管及支气管周围炎症。
胞内分枝杆菌组中,支气管扩张CT征象的发生率仅次于小叶中心结节。鸟分枝杆菌组及脓肿分枝杆菌组中支气管扩张出现的比例差异无统计学意义。堪萨斯分枝杆菌组出现支气管扩张最少。

▲图:56岁女性,支气管扩张型非结核分枝杆菌感染患者,侧位胸片显示不均匀的网状影以及中叶和舌段体积缩小。横轴位平扫CT显示广泛的支气管扩张及中叶和舌段体积缩小、多发细胞性细支气管炎、黏液栓,以及马赛克密度。(病例来自《肺部高分辨率CT》译者:赵绍宏 聂永康)

▲图:冠状位平扫CT显示下叶蜂窝影(来自肺纤维化),以及左肺上叶大的空洞。纤维空洞型非结核分枝杆菌感染通常见于肺气肿,以及右肺下叶小空洞。小空洞在胸上可很难辨认,可能由是同时存在的肺疾病。(病例来自《肺部高分辨率CT》译者:赵绍宏 聂永康)
空洞是4个菌种组中常见的CT征象,空洞是由支气管壁及周围炎症形成结节,管壁溃疡坏死后,坏死物经支气管排出后形成。堪萨斯分枝杆菌组出现空洞的比 例要明显高于其他3组,而且空洞更多见于右肺上叶。不同菌种组中空洞的好发部位有其特征性,空洞的发生部位对判断各菌种有一定意义。

▲NTM的厚壁空洞
小结
参考文献:
部分病例来源:
1、王安龙,司马斌,保春华.等.常见非结核分枝杆菌肺病的 MSCT 表现[J].健 康 研 究,2020,40(4):431-438.
2、《肺部高分辨率CT》译者:赵绍宏 聂永康
3、天等影像、天等放射诊断中心微信公众号
参考文献:
[1]刘文斌. 社区老年人高血压流行病学调查[J].中国全科医学, 2011,14( 3) : 300-302.
[2]陈露,史河水,曲世林,等.非结核分枝杆菌肺病的 MSCT 表现 [J].放射学实践,2018,28( 2) : 161-165.
[3]姚景江,贺亚琼,张亚林.非结核分枝杆菌肺病的临床与 MSCT 表 现[J].中国医学影像技术,2017,33( 3) : 414-418.
[4]王安龙,司马斌,保春华.等.常见非结核分枝杆菌肺病的 MSCT 表现[J].健 康 研 究,2020,40(4):431-438.
上一篇:胸部X线平片的漏诊陷阱
下一篇:肺炎支原体肺炎